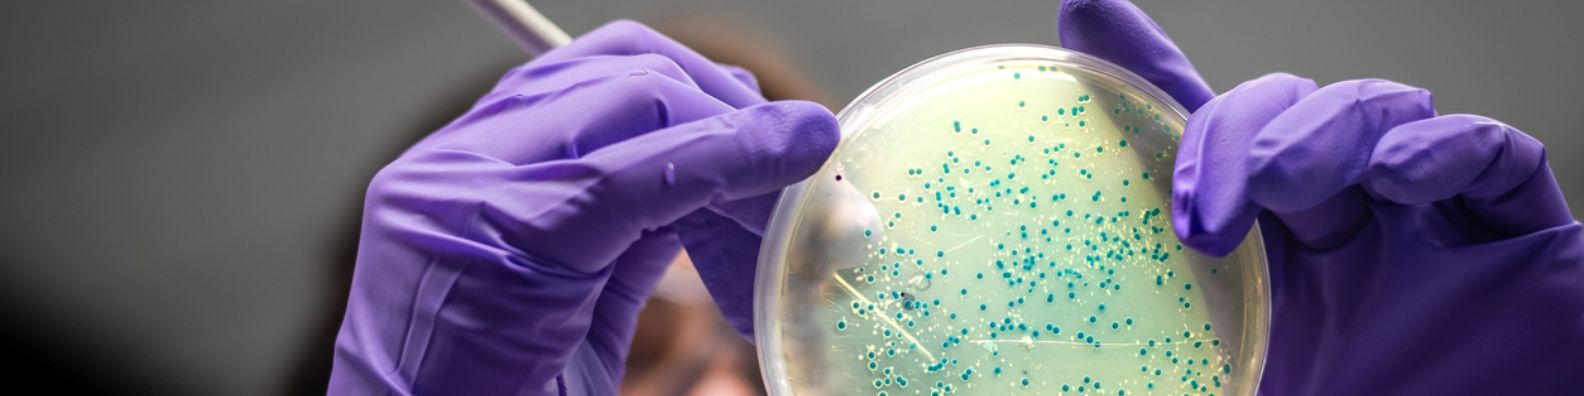
US BioPharma Giant uses AiRo’s Cost Optimization Framework to Reduce Expensive Cloud Bills

The client is globally the largest repository that manages standard reference microorganisms, cell lines, and other materials for research and development purposes.
The customer had slowly moved its business to the cloud. The transformation, however, didn’t follow any technique or adhere to adequate architectural preplanning. The client was consequently presented with a disproportionate cloud bill and little information regarding resource usage and expenditure.
Implementing Airo's cloud cost optimization strategy resulted in reduced Annual TCO from $4.3Mil to $2.8Mil, and a 45% Improvement in performance due to better application tuning.
There were no centralized optimization techniques or one organization in charge of the overall cost operation, and the client’s 16 verticals were all operated as independent business units. The client approached Airo to implement a cost-reduction strategy as their costs continued to rise.
Airo was able to map the major costs and pinpoint other areas for savings by closely monitoring Cloud costs and speaking with several important company personnel.
Based on both short- and long-term savings, Airo suggested annual savings of 28%, producing some rapid wins with long-term cost optimization. The Airo framework for the business featured an all-inclusive service in addition to cost optimization solutions:
Setting up an individual dashboard for resource owners to continuously monitor expenses and foster accountability.
The optimization process was somewhat drawn out and complex because there were 4 different Azure subscriptions with 15 sub-tenants. In addition to that, ‘Reserved Instances’ were applied to some sub-tenants. To complicate things further, various types of licensing were involved, including Pay-As-You-Go and CSP model.
Identified modernization candidates and built a prioritized list
Migrated all application to serverless architecture or containerized to ensure supportability on any platform
Created isolation using standard Azure AD capabilities
All serverless code deployed using DevOps pipelines
All new environments created using IaaC
Implementing Airo’s cloud cost optimization strategy resulted in reduced Annual TCO from $4.3Mil to $2.8Mil, and a 45% Improvement in performance due to better application tuning.